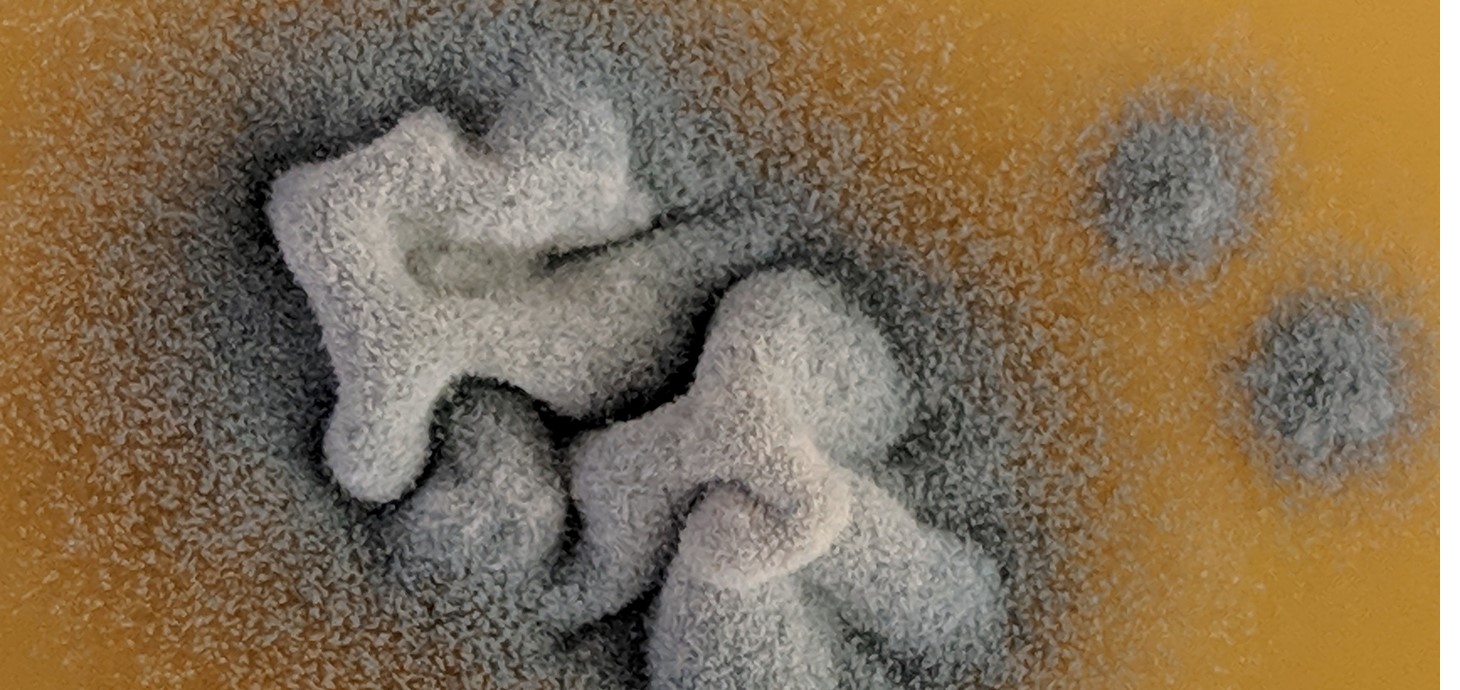

Mae'r erthyglau hyn bellach wedi'u harchifo ac ni fyddant yn cael eu diweddaru mwyach
Mae ymchwil ym Mhrifysgol Abertawe i'r bygythiad sy'n cael ei beri gan ymwrthedd i gyffuriau gwrthffwngaidd wedi cael ei hamlygu mewn dau gyfnodolyn o bwys.
Mae afiechydon ffwngaidd bellach yn lladd mwy o bobl na malaria neu TB ac mae'r Ganolfan Rheoli Afiechydon yn UDA yn cydnabod datblygiad ymwrthedd i gyffuriau lluosog ymysg ffyngau yn fygythiad lefel uchel.
Mae Dr Josie Parker a'r Athro Steve Kelly o'r Ganolfan ar gyfer Amrywiaeth Sytocrom P450 ym Mhrifysgol Abertawe wedi bod yn rhan o'r astudiaethau a ymchwiliodd i agweddau gwahanol ar ymwrthedd.
Mewn perthynas â'r papur cyntaf a gyhoeddwyd yn y Cyfnodolyn Meicrobioleg Americanaidd, mBio, buont yn gweithio gyda chyd-academyddion o Brifysgol Lausanne, dan arweiniad yr Athro Dominique Sanglard, i gymharu genomau cyfan er mwyn adnabod mwtaniadau allweddol sy'n ymwneud ag ymwrthedd, a'r cyffuriau sydd ar gael gan gynnwys asolau, amffoteresin B ac echinocandinau.
Roedd yr ail bapur, a gyhoeddwyd yn Nature Communications, yn ffrwyth cydweithrediad rhyngwladol dan arweiniad yr Athro Paul Bowyer a Dr Mike Bromley o Brifysgol Manceinion.
Archwiliodd ymwrthedd i gyffuriau yn y pathogen ffwngaidd ffilamentog, Aspergillus fumigatus. Gall anadlu sborau'r ffwng hwn i mewn o'r awyr achosi'r afiechyd dinistriol, asbergilosis ymledol, sy'n achosi mwy na 200,000 o heintiau sy'n peryglu bywyd bob blwyddyn.
Meddai'r Athro Kelly, sydd wedi bod yn ymchwilio ym maes ymwrthedd gwrthffwngaidd am dros 30 o flynyddoedd: "Rydym yn falch iawn o gyfrannu at y prosiectau ymchwil hyn a'u bod wedi cael eu cyhoeddi mewn cyfnodolion mor uchel eu parch.
"Bydd gwella ein dealltwriaeth o ymwrthedd i gyffuriau gwrthffwngaidd yn helpu i ddatblygu therapïau effeithiol, a allai achub bywydau, yn y dyfodol."
Comparative Genomics for the Elucidation of Multidrug Resistance in Candida lusitaniae Kannan A, Asner SA, Trachsel E, Kelly SL, Parker JE, Sanglard D. DOI: 10.1128/mBio.02512-19.
The negative cofactor 2 complex is a key regulator of drug resistance in Aspergillus fumigatus Furukawa T, van Rhijn N, Fraczek M, Gsaller F, Davies E, Carr P, Gago S, Fortune-Grant R, Rahman S, Gilsenan JM, Houlder E, Kowalski CH, Raj S, Paul S, Cook P, Parker JE, Kelly SL, Cramer RA, Latgé J-P, Moye-Rowley S, Bignell E, Bowyer P, Bromley MJ. Nature Communications. 2020, 427
